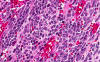

Online Slide/Full
Screen/
Open with Image Scope
|
|


Hematoxylin & eosin |
Area 1:
The tumor grow as a solid sheets composed of small blue cells. Although
small islands of neuropils can be seen (delimited by the white arrows),
genuine Homer Wright rosettes are not present. On high magniciation, you
can the fine fibrillary cytoplasmic background can be well appreciated.
They nuclei are hyperchromatic and the amount of cytoplasm is minimal. A
small but inconspicuous nucleoli is present in some of the nuclei. |
|

Hematoxylin & eosin |
Area
2: In this area, there are many pink
fibrovascular septa in between the tumor cells. When the leptomeninges
are involved by the tumor cells, the entrapped fibrovascular component
can give this histologic pattern. |
|

Hematoxylin & eosin |
Mitosis: Similar to other small blue cell tumors, mitotic figures
are not uncommon in medulloblastoma (arrows). High mitotic rate is also
a feature of the developing neuroepithelium. |
|
Hematoxylin & eosin |
Pyknotic nuclei: Many pyknotic nuclei (white arrow) are also
present in medulloblasta. These pyknotic nuclei may represent apoptotic
tumor cells and apoptosis is a characteristic of the developing
neuroepithelium. |
|